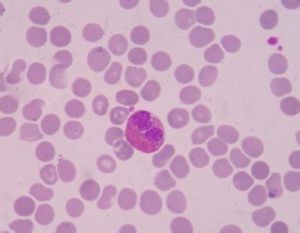
穩定細胞

基本內容
穩定細胞
穩定細胞
穩定細胞(
stable cells
)
生理情況下,細胞增殖現象不明顯,處於細胞增殖周期中的靜止期(
G
0),當受到組織損傷的刺激時可迅速轉入DNA合成前期(
G
1),表現出較強的再生能力的一類細胞,又稱
靜止細胞
(
 穩定細胞
穩定細胞quiescent cell
)。
這類細胞包括各種腺體或腺樣器官的實質細胞,如胰、涎腺、內分泌腺、汗腺、皮脂腺和腎小管的上皮細胞等,由其構成的組織處於分裂期的細胞低於1.5%。此類組織中的內分泌腺和上皮無幹細胞存在。目前認為,器官的再生能力是由其複製潛能決定的,而不是處於分裂期的細胞數量,如肝臟,處於分裂期的細胞數量低於一萬五千分之一,但在切除70%後,仍可快速再生。

